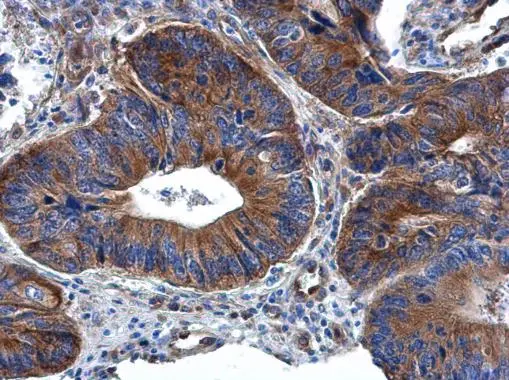
RPL32 antibody detects RPL32 protein at cytoplasm in human colon cancer by immunohistochemical analysis. Sample: Paraffin-embedded human colon cancer. RPL32 antibody (GTX130214) diluted at 1:500.
Antigen Retrieval: Citrate buffer, pH 6.0, 15 min RPL32 antibody detects RPL32 protein at cytoplasm in human colon cancer by immunohistochemical analysis. Sample: Paraffin-embedded human colon cancer. RPL32 antibody (GTX130214) diluted at 1:500.
Antigen Retrieval: Citrate buffer, pH 6.0, 15 min

RPL32 antibody detects RPL32 protein at cytoplasm by immunohistochemical analysis. Sample: Paraffin-embedded mouse brain. RPL32 stained by RPL32 antibody (GTX130214) diluted at 1:500. Antigen Retrieval: Citrate buffer, pH 6.0, 15 min
RPL32 antibody
GTX130214
ApplicationsImmunoFluorescence, Western Blot, ImmunoCytoChemistry, ImmunoHistoChemistry, ImmunoHistoChemistry Paraffin
Product group Antibodies
ReactivityHuman, Mouse, Rat
TargetRPL32
Overview
- SupplierGeneTex
- Product NameRPL32 antibody
- Delivery Days Customer9
- Application Supplier NoteWB: 1:500-1:3000. ICC/IF: 1:100-1:1000. IHC-P: 1:100-1:1000. *Optimal dilutions/concentrations should be determined by the researcher.Not tested in other applications.
- ApplicationsImmunoFluorescence, Western Blot, ImmunoCytoChemistry, ImmunoHistoChemistry, ImmunoHistoChemistry Paraffin
- CertificationResearch Use Only
- ClonalityPolyclonal
- Concentration1.46 mg/ml
- ConjugateUnconjugated
- Gene ID6161
- Target nameRPL32
- Target descriptionribosomal protein L32
- Target synonymsL32, PP9932, eL32, large ribosomal subunit protein eL32, 60S ribosomal protein L32
- HostRabbit
- IsotypeIgG
- Protein IDP62910
- Protein NameLarge ribosomal subunit protein eL32
- Scientific DescriptionRibosomes, the organelles that catalyze protein synthesis, consist of a small 40S subunit and a large 60S subunit. Together these subunits are composed of 4 RNA species and approximately 80 structurally distinct proteins. This gene encodes a ribosomal protein that is a component of the 60S subunit. The protein belongs to the L32E family of ribosomal proteins. It is located in the cytoplasm. Although some studies have mapped this gene to 3q13.3-q21, it is believed to map to 3p25-p24. As is typical for genes encoding ribosomal proteins, there are multiple processed pseudogenes of this gene dispersed through the genome. Alternatively spliced transcript variants encoding the same protein have been observed for this gene. [provided by RefSeq]
- ReactivityHuman, Mouse, Rat
- Storage Instruction-20°C or -80°C,2°C to 8°C
- UNSPSC41116161



![RPL32 antibody detects RPL32 protein at endoplasmic reticulum by immunofluorescent analysis. Sample: HeLa cells were fixed in 4% paraformaldehyde at RT for 15 min. Green: RPL32 stained by RPL32 antibody (GTX130214) diluted at 1:500. Red: alpha Tubulin, a cytoskeleton marker, stained by alpha Tubulin antibody [GT114] (GTX628802) diluted at 1:1000. Blue: Fluoroshield with DAPI (GTX30920). RPL32 antibody detects RPL32 protein at endoplasmic reticulum by immunofluorescent analysis. Sample: HeLa cells were fixed in 4% paraformaldehyde at RT for 15 min. Green: RPL32 stained by RPL32 antibody (GTX130214) diluted at 1:500. Red: alpha Tubulin, a cytoskeleton marker, stained by alpha Tubulin antibody [GT114] (GTX628802) diluted at 1:1000. Blue: Fluoroshield with DAPI (GTX30920).](https://www.genetex.com/upload/website/prouct_img/normal/GTX130214/GTX130214_44573_20220429_ICC_IF_w_23060523_514.webp)

![RPL32 antibody [HL2329] detects RPL32 protein at cytoplasm by immunofluorescent analysis. Sample: HeLa cells were fixed in ice-cold MeOH for 5 min. Green: RPL32 stained by RPL32 antibody [HL2329] (GTX638492) diluted at 1:500. Red: alpha Tubulin, a cytoskeleton marker, stained by alpha Tubulin antibody [GT114] (GTX628802) diluted at 1:1000. Blue: Fluoroshield with DAPI (GTX30920).](https://www.genetex.com/upload/website/prouct_img/normal/GTX638492/GTX638492_T-45005_20230512_ICC_IF_23060622_725.webp)
![Various tissue extracts (50 μg) were separated by 15% SDS-PAGE, and the membrane was blotted with RPL32 antibody [HL2331] (GTX638494) diluted at 1:1000. The HRP-conjugated anti-rabbit IgG antibody (GTX213110-01) was used to detect the primary antibody.](https://www.genetex.com/upload/website/prouct_img/normal/GTX638494/GTX638494_T-45005_20230421_WB_M_R_23042500_392.webp)

